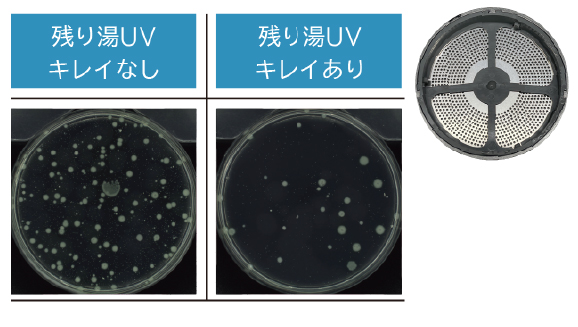

UV除菌(LED)
入浴後のお湯の除菌※1や残り湯洗濯のニオイも抑制※2!
浴槽のお湯をキレイにする UVキレイ入浴
入浴の状況に応じて自動でUV運転を開始。給湯器が浴槽のお湯を取り込みUVを照射した上で、キレイになったお湯を再度浴槽に送るので、家族が入った後でも気持ちよく入浴することができます。
さらにUV除菌ユニットがLED化したことにより、退浴後5分間UV運転が働く「退浴検知運転」が可能になりました。


LED-UV除菌ユニットの仕組み
浴槽の循環アダプターから残り湯を吸い込み、給湯器内のLED-UV除菌ユニットでUV照射。キレイになったお湯を再び浴槽へ。
キレイなお湯で翌日に洗濯できる残り湯UVキレイ
最後の方の入浴終了後、翌朝の予約時間まで断続的にUV運転を行います。
菌の増殖を99%抑制※3した残り湯で洗濯できるため、部屋干し時のニオイの発生を抑制します。

菌の抑制 ニオイ比較※2

比較 お湯の濁度※4

菌数測定比較(循環アダプタ蓋裏面)※5
UV除菌(LED)対応機種
- ※プレミアムのみ。
- ※RC-KWリモコン組み合わせ時のみ。
- ※プレミアムのみ。
- ※RC-KWリモコン組み合わせ時のみ。
- ※プレミアムのみ。
- ※RC-KWリモコン組み合わせ時のみ。
ガスふろ給湯器 GT-70-1シリーズ(PDF:5,369B)
- ※プレミアムのみ。
- ※RC-KWリモコン組み合わせ時のみ。
- ◆「LED-UV除菌ユニット」は除菌するものであり、汚れを落とすものではありません。また全ての菌に作用するものではありません。
- ※1[試験機関](株)衛生微生物研究センター[試験番号]2021D-BT-10075[試験方法]180L、40℃の試験液が入った試験浴槽においてLED-UV除菌ユニットを循環運転。流量9.5L/min。
[試験結果]72分後で99%以上抑制。(実使用での実証結果ではありません。使用環境により効果は異なります。) - ※2[試験機関](株)衛生微生物研究センター[試験番号]28D-BT-273[試験方法]におい原因菌が付着した試験布を6段階臭気強度表示法にて評価。
[試験結果]「1.5X106(cfu/mL)の試験液に浸した布」:臭気強度4、「1.8X104(cfu/mL)の試験液に浸した布」:臭気強度1(実使用での実証効果ではありません。全ての菌に効果があるわけではありません。菌の種類・対象物の素材により効果は異なります。) - ※3[試験機関](株)衛生微生物研究センター[試験番号]2021D-BT-10075[試験方法]180L、40℃の試験液が入った試験浴槽において「残り湯UVキレイ」を実施。流量9.5L/min。
[試験結果]14時間後、運転なしとの比較で99%以上抑制。(実使用での実証効果ではありません。使用環境により効果は異なります。) - ※4[試験機関](株)ノーリツ[試験方法]180L、4人入浴。(使用環境により効果は異なります。)
- ※5[試験機関](株)ノーリツ[試験方法]おとな4人が180L、40℃設定のふろに各10分間入浴。「残り湯UV キレイあり」の場合と「残り湯UV キレイなし」の場合の、循環アダプタ裏面を検査キットで拭き取り、残存した菌数を測定。[菌数測定機関](株)総合水研究所[試験番号]N2501177(実使用での実証実験ではありません。使用環境により効果は異なります。)


